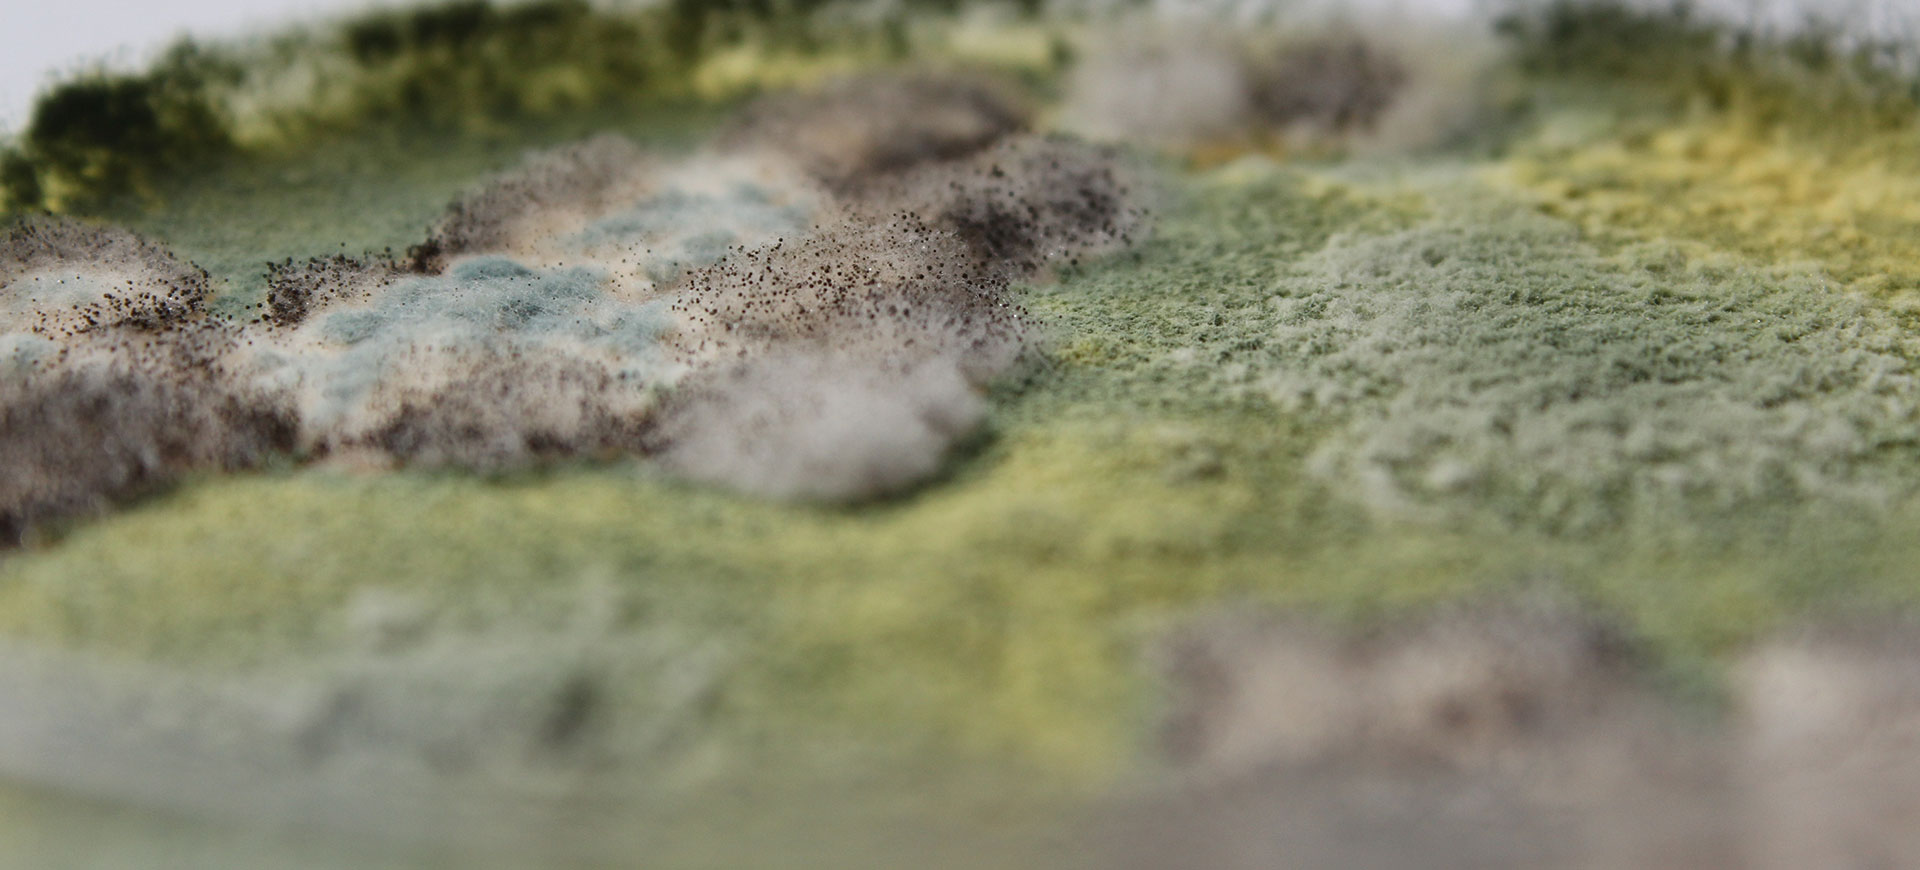

需要详细沟通防霉抗菌产品和技术支持
联系电话:+86 18102206864
联系电话:+86 18102206864










阳离子防霉专利技术,通过“化学键+静电结合”的方式,长久绑定在物体表面带有正电荷,可主动吸附带负电荷的霉菌,长碳链结构像尖刀一样刺破霉菌的细胞壁,破环霉菌正常生理活动,使其无法繁殖,确保产品不发生霉变。





 高效除霉
高效除霉